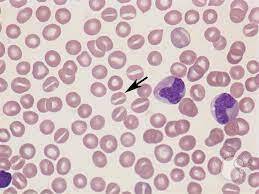
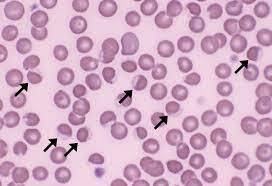
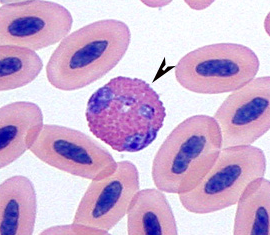
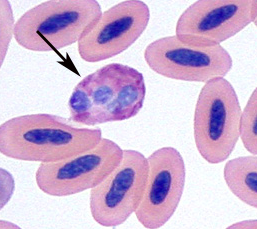
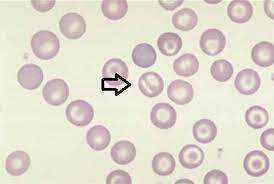
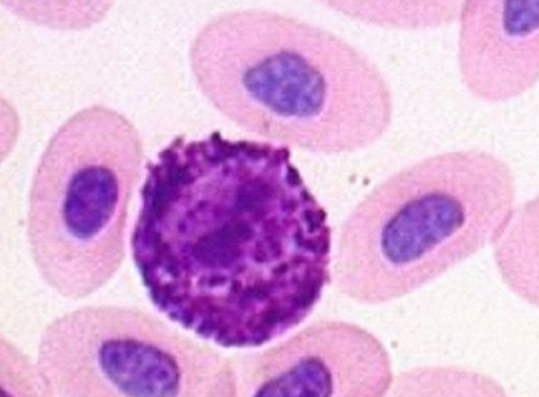
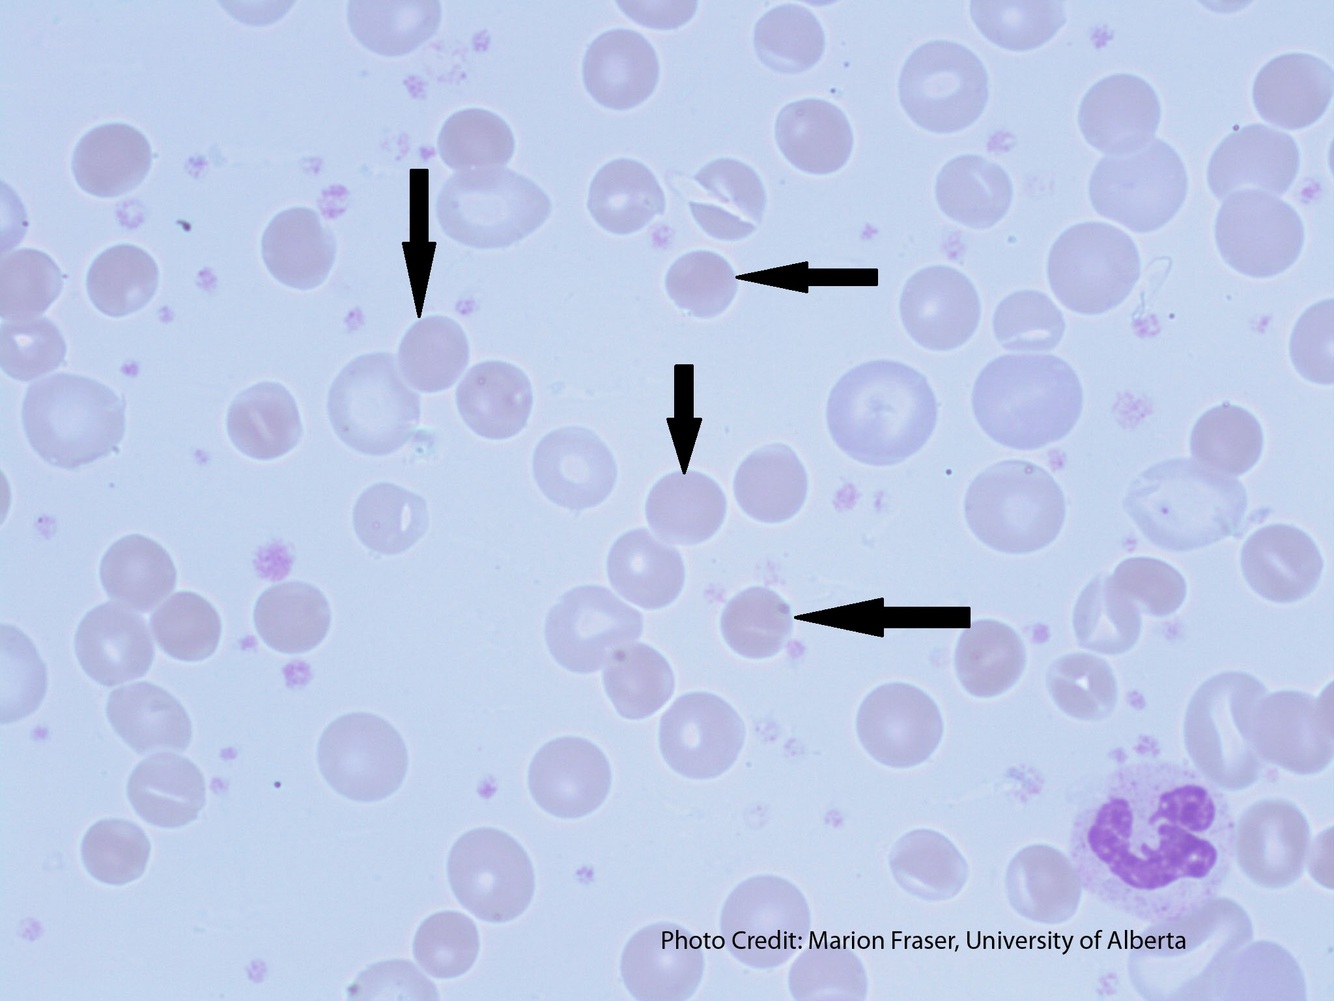
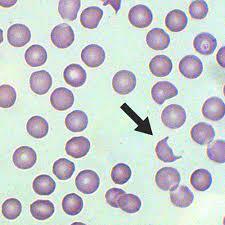
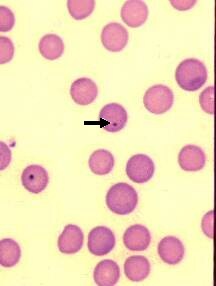
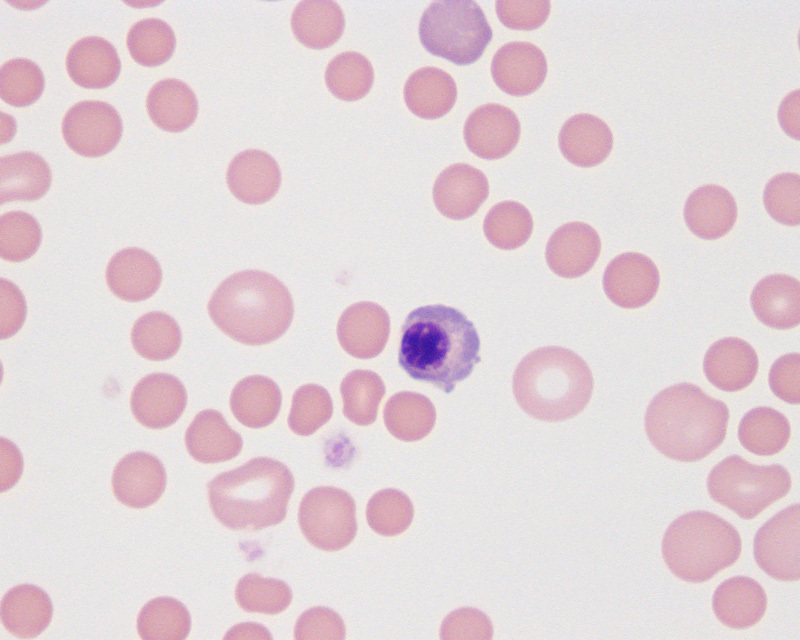
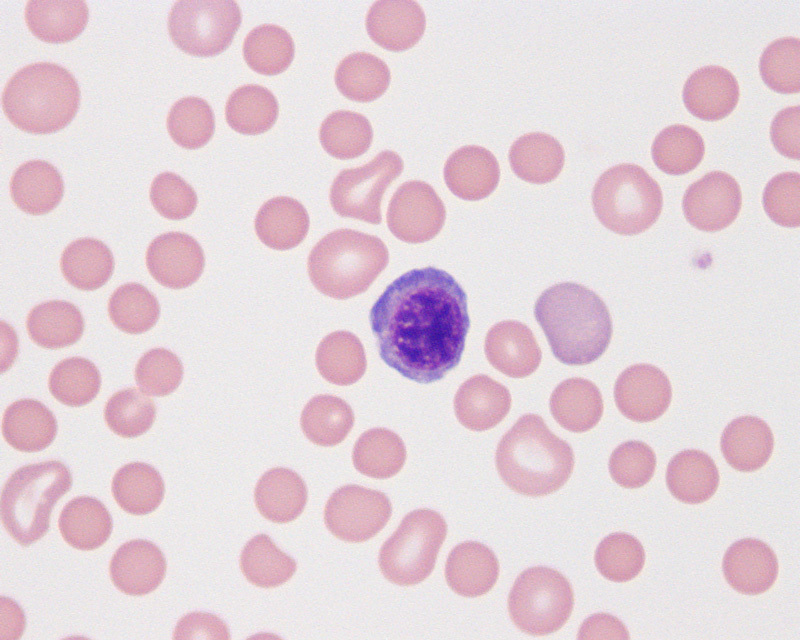
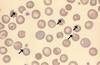
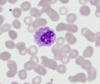
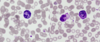
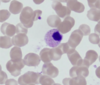
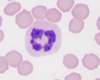
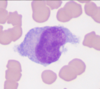
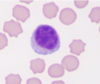

Stomatocyte
* coffee bean look
* cell folded
* usually seen with hypochromasia

Acanthocytes
* uneven distributions
* see with hemolytic anemia, liver disease, hemangiosarcoma, or DIC
Eccentrocyte
* hemoglobin concentrated to one side of cell
* oxidative injury of RBC
* Dog: zinc or onion toxicity
* Cat: tylenol, lymphoma, diabetes, hyperthyroid
Avian Eosinophil
* Round cell, light blue cytoplasm
* Granule size varies with species, but will be uniform within same patient
* Granules brighter than heterophils
Avian Heterophil
* Correspond to neutrophils
* Most common WBC in birds
* Round cell, colorless cytoplasm
* Brick red / rod shaped granules
* 2-3 lobed nucleus

Promyelocyte
* WBC series
* 2nd in line
* large nucleus
* nucleoli may be present
* pink/red granules noted

Prorubricyte
* RBC series
* 2nd in series
* nuclear material dense and clumped
* basophilic cytoplasm

Multinucleation
* multiple nuclei within cell
Barr Cell - Knizocyte

Megakaryocyte
* platelet series
* multiple condensed nuclei
* large size
* not counted in M:E ratio
Avian Basophil
* Small round cell
* Centrally located nucleus
* Nucleus often hidden by granules
* Granules are deeply basophilic
* Cytoplasm (if seen) is colorless to light purple/red

Starfish Smear
* doesn’t damage fragile cells
* can have thick, unreadable areas

Myelocyte
* WBC series
* 3rd in line
* greater nucleus-to-cytoplasm ratio
* granules throughout cytoplasm
* where distinction of E, N, B
Spherocytes
* lack central pallor
* macrophages partially eating antibody coating on cell
* see in IMHA

Compression Smear
* do not apply downward pressure - can lead to ruptured cells

Metamyelocyte
* granules present in cytoplasm
* nucleus indented or “kidney-bean” shape
* nucleus smaller than before
* cytoplasm a lighter blue
Schistocytes
* fragments of RBCs sheared from intravascular trauma
* see with DIC

Rubriblast
* RBC series
* most immature
* large cell with large nucleus
* multiple nucleoli
* basophilic cytoplasm
* possible mitotic figures
Howell-Jolly Bodies
* nuclear remnant inside RBC
* sign of regeneration
* if no reticulocytes seen, consider macrophage dysfunction (splenic)
Metarubricyte
* RBC series
* also called nRBCs
Rubricyte
* RBC series
* 3rd in line
* hemoglobin being produced
* polychromatophilic
* blue/pink cytoplasm

Myeloblasts
* WBC steries
* most immature
* multiple nucleoli
* large nucleus
* scant cytoplasm

Line Smear
* similar to blood, but lift straight up at the end
* best if sample has low cellularity
* line will be very cellular

Echinocytes
* even distributions
* caused by crenation or too much EDTA
* sign of renal disease